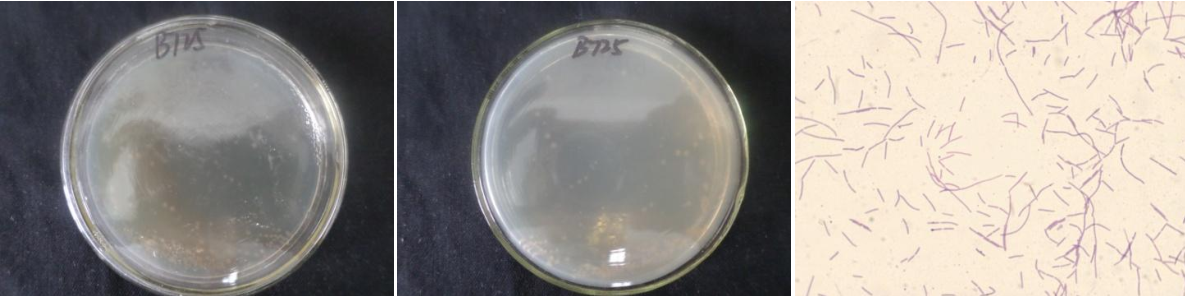

Loading...
| StrainNO | B725 |
| Classification | Ochrobactrum |
| 16s rDNA sequence | TTGCGGCAGCTTACCATGCAGTCGAGCGCCCCGCAAGGGGAGCGGCAGACGGGTGAGTAACGCGTGGGAATCTACCTTTTGCTA CGGAATAACTCAGGGAAACTTGTGCTAATACCGTATGTGCCCTTCGGGGGAAAGATTTATCGGCAAAGGATGAGCCCGCGTTGG ATTAGCTAGTTGGTGAGGTAAAGGCTCACCAAGGCGACGATCCATAGCTGGTCTGAGAGGATGATCAGCCACACTGGGACTGAG ACACGGCCCAGACTCCTACGGGAGGCAGCAGTGGGGAATATTGGACAATGGGCGCAAGCCTGATCCAGCCATGCCGCGTGAGTG ATGAAGGTCTTAGGATTGTAAAGCTCTTTCACCGGTGAAGATAATGACGGTAACCGGAGAAGAAGCCCCGGCTAACTTCGTGCC AGCAGCCGCGGTAATACGAAGGGGGCTAGCGTTGTTCGGATTTACTGGGCGTAAAGCGCACGTAGGCGGACTTTTAAGTCAGGG GTGAAATCCCGGGGCTCAACCCCGGAACTGCCTTTGATACTGGAAGTCTTGAGTATGGTAGAGGTGAGTGGAATTCCGAGTGTA GAGGTGAAATTCGTAGATATTCGGAGGAACACCAGTGGCGAAGGCGGCTCACTGGACCATTACTGACGCTGAGGTGCGAAAGCG TGGGGAGCAAACAGGATTAGATACCCTGGTAGTCCACGCCGTAAACGATGAATGTTAGCCGTCGGGGAGTTTACTCTTCGGTGG CGCAGCTAACGCATTAAACATTCCGCCTGGGGAGTACGGTCGCAAGATTAAAACTCAAAGGAATTGACGGGGGCCCGCACAAGC GGTGGAGCATGTGGTTTAATTCGAAGCAACGCGCAGAACCTTACCAGCCCTTGACATACCGGTCGCGGACACAGAGATGTGTCT TTCAGTTCGGCTGGACCGGATACAGGTGCTGCATGGCTGTCGTCAGCTCGTGTCGTGAGATGTTGGGTTAAGTCCCGCAACGAG CGCAACCCTCGCCTTTAGTTGCCATCATTTAGTTGGGCACTCTAAAGGGACTGCCAGTGATAAGCTGGAGGAAGGTGGGGATGA CGTCAAGTCCTCATGGCCCTTACGGGCTGGGCTACACACGTGCTACAATGGTGGTGACAGTGGGCAGCAAGCACGCGAGTGTGA GCTAATCTCCAAAAGCCATCTCAGTTCGGATTGCACTCTGCAACTCGAGTGCATGAAGTTGGAATCGCTAGTAATCGCGGATCA GCATGCCGCGGTGAATACGTTCCCGGGCCTTGTACACACCGCCCGTCACACCATGGGAGTTGGTTCTGCCCGAAGGCACTGTGC TAACCGTAAGGAGGCAGGGACCACGTAGTACGCCT |
| Strain Morphology Photos | |
| Morphological Description | Colony round;orange;edge serrated;drying;wrinkled;bright;sticky;Bacteriophage Rod-shaped;no spore |